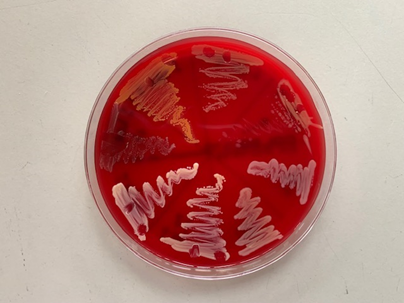

Kiemdetectie in de melk met sneltesten laat toe om gerichter te beslissen om melkkoeien mét of zonder antibiotica droog te zetten. Op het ILVO proefbedrijf werd begin 2023 gestart met selectief droogzetten na snelle kiemdetectie. Na één jaar blijkt het gebruik van antibiotica bij droogzetten gehalveerd. Na aanpassen van het protocol bleven ook het aantal mastitisgevallen en het tankcelgetal op een vergelijkbaar niveau.
Creatief met vervallende sneltesten
In het kader van VLAIO project ‘On Practice Culture’ wordt onderzocht of niet-ernstige klinische mastitis bij melkkoeien selectief behandeld kan worden. Kiemdetectie in de melk met sneltesten kunnen na 18 tot 24 uur al afgelezen worden en op basis van het verkregen resultaat wordt de koe al of niet met antibiotica behandeld. Op het ILVO melkveebedrijf kwamen in de geplande proefperiode echter weinig koeien met milde klinische mastitis in aanmerking om te testen. Om te voorkomen dat de beschikbare sneltesten onbenut blijven en hun houdbaarheidsdatum overschrijden, werd beslist ze ook te gebruiken bij droogzetten.

Hoe selectief droogzetten na kiemdetectie
Op het ILVO proefbedrijf worden koeien standaard drooggezet volgens het Keno-M advies. Dit advies houdt per koe rekening met mastitisgevallen in het verleden en het celgetal bij de laatste 3 MPR analyses: groen voor een koe met laag celgetal die dus zonder antibiotica kan drooggezet worden en rood voor een koe met verhoogd celgetal die beter wel met antibiotica wordt behandeld tijdens droogzetten. De resultaten van de sneltesten dienen als een extra verfijning van dit advies.
Eén week voor droogzetten wordt per koe van alle uierkwartieren een melkstaal genomen. Deze stalen ondergaan een CMT test (California Mastitis Test) om kwartieren met een verhoogd celgetal op te sporen. In deze test wordt het celgetal weerspiegeld in een bepaalde graad van verslijming. Hoe sterker de gelvorming, hoe hoger het celgetal van de melk. Bij de minste vorm van verslijming worden deze stalen uitgeplaat op de sneltesten om de kiemen te detecteren en identificeren. Na amper 18 tot 24 uur kan het resultaat al afgelezen worden.
Als er geen bacteriegroei is (bijvoorbeeld bij gisten, schimmels of wanneer er effectief geen kiem aanwezig is) of het melkstaal bevat ‘niet-Aureus Stafylokokken’ (NAS) of Corynebacterium bovis, dan wordt beslist om deze kwartieren zonder antibiotica te behandelen. Ook de kwartieren zonder verslijming (negatieve CMT test) en met een groen Keno-M advies worden zonder antibiotica behandeld.
Wijst het resultaat van de sneltest op een poly-bacteriële besmetting, een gram negatieve kiem (bvb coliformen) of ‘major pathogen’ (Staphylococcus Aureus, Streptococcus uberis, Streptococcus agalactiae, Streptococcus dysgalactiae of Trueperella pyogenes), dan wordt wel met antibiotica drooggezet. Ook als de CMT-test negatief is, terwijl het Keno-M advies rood is, wordt de koe op de vier kwartieren met antibiotica drooggezet. De CMT test blijkt immers onvoldoende gevoelig om kwartieren met licht verhoogd celgetal te detecteren. Tot november 2023 werden op het ILVO melkveebedrijf koeien met rood Keno-M advies drooggezet zonder antibiotica als hun CMT test op vier kwartieren negatief was. Na een verhoging in het aantal mastitis gevallen en van het gemiddeld tankcelgetal, werd het protocol evenwel aangepast.
Gebruik antibiotica daalt drastisch na selectief droogzetten
Na een jaar selectief droogzetten na kiemdetectie blijkt het gebruik van antibiotica bij droogzetten op het ILVO melkveebedrijf drastisch gedaald. Ten opzichte van het gemiddeld verbruik van uiertubes met antibiotica in de jaren 2020 – 2022 lag het verbruik ervan in 2023 zo’n 50 % lager. Het aantal mastitisgevallen en het gemiddeld celgetal in 2023 lag evenwel iets hoger dan de jaren voordien. Dit was in hoofdzaak het gevolg van enkele mastitisgevallen na droogzetten zonder antibiotica op basis van een negatieve CMT-test, terwijl het Keno-M advies rood was. Het is dus aan te bevelen steeds het Keno-M advies te volgen en de CMT en sneltesten te gebruiken om de behandeling te verfijnen tot op kwartierniveau. Zo maakt kiemdetectie via sneltesten het mogelijk nog selectiever droog te zetten zonder antibiotica, zonder de gezondheid van de koeien nadelig te beïnvloeden.
Kiemdetectie: op het melkveebedrijf of op de dierenartsenpraktijk
In het VLAIO project ‘On Practice Culture’ wordt ook onderzocht hoe een correcte kiemdetectie vlot georganiseerd kan worden. De detectie moet immers snel, maar zeker ook correct uitgevoerd worden. Het nemen en verwerken van de melkstalen vergt heel wat technische kennis en voldoende routine bij uitvoeren van de verschillende handelingen is zeker aangewezen. Ervaring in de praktijk toont aan dat, zelfs na een grondige opleiding, heel wat oefening nodig is om voldoende bruikbare resultaten te genereren. Verwerken van de stalen in de dierenartsenpraktijk zal in veel gevallen dan ook de beste resultaten opleveren.
Conclusie
De voorlopige resultaten geven aan dat kiemdetectie in melkstalen aan de hand van sneltesten het gebruik van antibiotica gevoelig zou kunnen verlagen door melkkoeien verantwoord selectief droog te zetten. Een correct opgesteld en uitgevoerd protocol kan het antibioticagebruik in de melkveehouderij verder reduceren zonder de gezondheid van de koeien of de melkproductie aan te tasten. Een goede opleiding en secure aanpak bij het nemen van de melkstalen verhogen de betrouwbaarheid van de sneltest. Verzamelen van de melkstalen van meerdere melkveebedrijven en centraal verwerken in een dierenartsenpraktijk lijkt dus zeker een geschikte manier om tot goede resultaten te komen.

Bron: Rundveeloket











